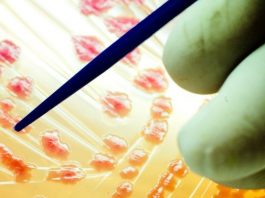

Специалисты изучают звуковые коммуникации пираньи в темных водах
Пираньи весьма широко известны в качестве кровожадных маленьких рыб с малыми острыми зубами и большим аппетитом – однак...
Ученые нашли «секретный» коралловый риф в реке
Амазонка, река в Южной Америке имеющая протяженность 7000 километров, постоянно удивляет исследователей. На данный момен...
Человеческие клетки регенерируют сердце примата
Удается отметить значительный прорыв в лечении сердечнососудистых заболеваний. Ученым из университета штата Вашингтон уд...
В поисках лучшего лечения болезни меньера ученые пришли к стероидам
Болезнь меньера крайне изнурительна, она вызывает очень сильные головокружения при которых больной не способен удержатьс...
Рак можно победить программируемыми клетками-макрофагами
Исследователи из Института Каролинска сумели выделить специальные антитела, которые умеют перепрограммировать набор кле...
Ученых удивили предки-вегетарианцы современного крокодила
Достаточно сложно представить, чтобы современный крокодил или любое другое подобное животное предпочитало бы питаться р...
Раскрыт необычный факт о доисторических китах
Раскрытие различных тайн доисторических обитателей суши и моря становится нередко той темой преткновения интересов разл...
Гарвардские ученые прояснили взаимосвязь между плохим сном и сердечными заболеваниями
Недостаток сна и плохое его качество могут отрицательно сказаться не только на настроении человека, но также на его здо...
Прерывистый пост может предотвратить развитие диабета
Прерывистое голодание, с недавних пор являющееся одним из наиболее заметных трендов в индустрии здорового питания и обр...
Федеральная Комиссия FDA отозвала еще несколько партий метформина
Использование некоторых распространенных лекарств в течение длительного времени может так или иначе вызывать ранее необ...